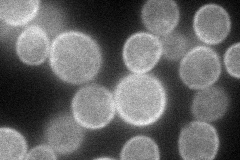
YDR459C
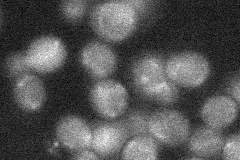
YDR459C
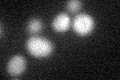
YDR459C

View description
Palmitoyltransferase with autoacylation activity; likely functions in pathway(s) outside Ras; member of a family of putative palmitoyltransferases containing an Asp-His-His-Cys-cysteine rich (DHHC-CRD) domain
Localization:
Intensity:
Fold change:
Significance:
-
C’ GFP library in SD

below threshold14.78 -
N' NOP1pr-GFP in SD
cell periphery65.2894 -
N' TEF2pr-mCherry in SD

cell periphery,vacuole102.676 -
N' NATIVEpr-GFP in SD
below threshold20.7806 -
N' TEF2pr-VC and Cyto-VN in SD

below threshold27.3468 -
C’ GFP library in SD+DTT
cytosol16.41.1No -
C’ GFP library in SD+H2O2

cytosol16.611.12No -
C’ GFP library in Starvation Media

cytosol18.591.25No -
C’ GFP library on the background of Pup2-DaMP

N/A -
C’ GFP library on the background of CCT mutant

N/A0N/AYes
